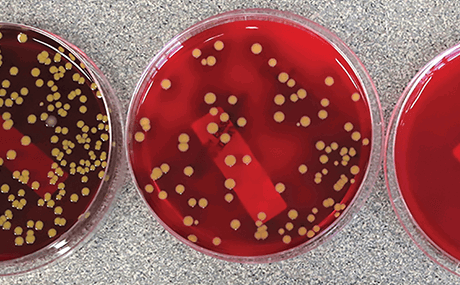
{4CFDC0F1-0E00-40DD-88A5-5C1EF087FD25}/

La demanda de dispositivos médicos impresos en 3D que se puedan utilizar en intervenciones quirúrgicas sigue aumentando. En este documento técnico, se habla sobre un revestimiento antimicrobiano basado en agua y disponible comercialmente que puede reducir o eliminar las bacterias de los dispositivos impresos en 3D sin necesidad de usar autoclaves. Los resultados de las pruebas incluyen datos para las piezas impresas en 3D con: